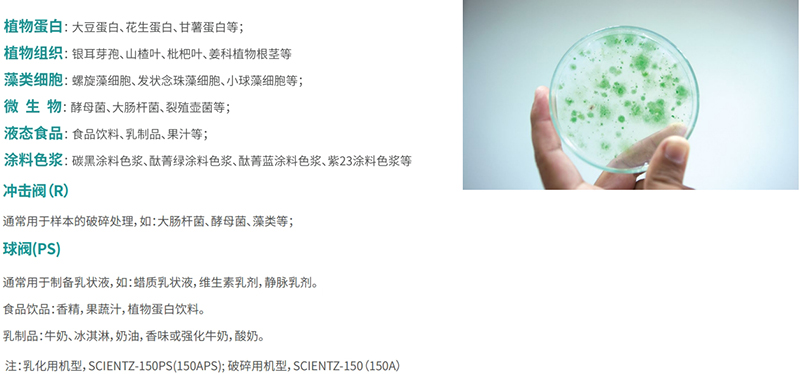
樣本舉例

920685
高壓均質(zhì)機(jī)是一種小型化的臺(tái)式生物樣品處理裝置。本機(jī)內(nèi)置冷卻循環(huán)系統(tǒng),直接冷卻均質(zhì)頭,并可選購(gòu)不同應(yīng)用的均質(zhì)閥。具有壓力高、體積小、操作方便、處理效率高及出樣量較大等特點(diǎn)。每小時(shí)6-12升,最高工作壓力1500bar,馬達(dá)功率1.5KW8級(jí),供電電源220V/50Hz,最大產(chǎn)品粘度2000cP,最高產(chǎn)品溫度為90℃。
我公司推出的高壓均質(zhì)機(jī)是一種小型化的臺(tái)式生物樣品處理裝置。本機(jī)內(nèi)置冷卻循環(huán)系統(tǒng),直接冷卻均質(zhì)頭,并可選購(gòu)不同應(yīng)用的均質(zhì)閥。具有壓力高、體積小、操作方便、處理效率高及出樣量較大等特點(diǎn)。是生物工程及生物制藥等行業(yè)研發(fā)及生產(chǎn)的標(biāo)準(zhǔn)設(shè)備。
物料由物料杯經(jīng)單向閥進(jìn)入高壓倉(cāng),通過(guò)柱塞伸縮加壓使樣品達(dá)到所調(diào)節(jié)控制的高壓下,通過(guò)特定寬度的限流縫隙瞬間釋放形成微射流撞擊沖擊閥或均質(zhì)閥上,依次經(jīng)過(guò)空穴、撞擊、剪切的作用來(lái)達(dá)到物料的乳化分散和細(xì)胞粉碎機(jī)的目的。


? 破碎效率高 生物樣品物料粒徑可均勻細(xì)化到100nm以下,破碎率大于95%
? 壓力可調(diào)節(jié) 設(shè)計(jì)均質(zhì)壓力0~150Mpa任意可調(diào)
? 流量可調(diào) 變頻流量控制系統(tǒng),可根據(jù)需要調(diào)節(jié)流量大小
? 在線排氣 操作簡(jiǎn)單,排氣后自動(dòng)恢復(fù)所調(diào)節(jié)壓力
? 衛(wèi)生級(jí)別高 采用符合食品藥品要求的316L不銹鋼材料
? 零殘留 內(nèi)置排空閥結(jié)構(gòu)可排空物料
? 溫度可控 冷卻接頭進(jìn)出口與恒溫槽相接,有效控制均質(zhì)物料溫度上升
? 發(fā)明專利 內(nèi)置冷卻器結(jié)構(gòu)設(shè)計(jì)
? 多功能選配 可選配柱塞清洗功能,延長(zhǎng)柱塞密封圈壽命;可選配自動(dòng)調(diào)壓功能,使用方便快捷
? 質(zhì)量好 壓力穩(wěn)定壽命高
生物工程
處理微生物樣品及藻類細(xì)胞的破碎,在不同的均質(zhì)條件下,對(duì)植物蛋白功能性影響的研究
食品工程
研究不同的均質(zhì)條件對(duì)食品、飲料理化性質(zhì)方面的影響,非加熱型殺菌技術(shù)在液態(tài)食品中的應(yīng)用
材料工程
在顏料染料超細(xì)粉碎加工處理中的應(yīng)用,化妝品(納米粒乳液、脂質(zhì)體)工藝的優(yōu)化
生物制藥
優(yōu)化有效藥物成分(脂肪乳、納米懸浮液、脂質(zhì)納米粒、脂質(zhì)體、黃酮類化合物)的提取及制備工藝,中藥提取物與現(xiàn)代制藥新技術(shù)融合的研究
的提取及制備工藝
? 植物蛋白 大豆蛋白、花生蛋白、甘薯蛋白等;
? 植物組織 銀耳芽孢、山楂葉、枇杷葉、姜科植物根莖等;
? 藻類細(xì)胞 螺旋藻細(xì)胞、發(fā)狀念珠藻細(xì)胞、小球藻細(xì)胞等;
? 微生物 酵母菌、大腸桿菌、裂殖壺菌等;
? 液態(tài)食品 食品飲料、乳制品、果汁等;
? 涂料色漿 碳黑涂料色漿、酞菁綠涂料色漿、酞菁藍(lán)涂料色漿、紫23涂料色漿等;
? 沖擊閥(R) 通常用于樣本的破碎處理,如:大腸桿菌、酵母菌、藻類等;
? 球閥(PS) 通常用于制備乳狀液,如:蠟質(zhì)乳狀液,維生素乳劑,靜脈乳劑;
食品飲品:香精,果蔬汁,植物蛋白飲料;
乳制品:牛奶、冰淇淋,奶油,香味或強(qiáng)化牛奶,酸奶;
| 型號(hào) | SCIENTZ-150(150PS) | SCIENTZ-150A(150APS) |
| 供電電源 | 220V/50Hz | 三相四線制 380V/50Hz |
| 流量 | 6-12升/小時(shí) | 12-25升/小時(shí) |
| 每分鐘抽吸次數(shù) | 約140次 | 約140次 |
| 最高工作壓力 | 1500bar | 1500bar |
| 最大產(chǎn)品粘度 | 2000cP | 2000cP |
| 馬達(dá)功率 | 1.5KW 8級(jí) | 3.0KW 8級(jí) |
| 整體尺寸 | L800*W460*H450mm | L840*W620*H540mm |
| 壓力顯示 | 七寸觸摸屏 | 壓力表數(shù)顯 |
| 最高產(chǎn)品溫度 | 90℃ | 90℃ |
| 最高蒸汽溫度 | 121℃ | 121℃ |
| 最大進(jìn)料顆粒 | 小于500微米 | 小于500微米 |
24小時(shí)服務(wù)熱線 18106650612